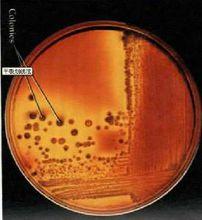
劃線培養法

劃線培養法:
1、微生物樣品稀釋;
2、用針尖沾取少量的稀釋液在固體培養基上畫線;
3、挑選所需特徵菌落,經過幾次相同的培養,最終得到了純種。
 劃線培養法
劃線培養法 劃線培養法
劃線培養法劃線培養法
劃線培養法
劃線培養法是實驗室培養菌落的一種方法。
劃線培養法:
1、微生物樣品稀釋;
2、用針尖沾取少量的稀釋液在固體培養基上畫線;
3、挑選所需特徵菌落,經過幾次相同的培養,最終得到了純種。
 劃線培養法
劃線培養法 劃線培養法
劃線培養法劃線培養法
劃線培養法四區劃線分離法是指把混雜在一起的微生物或同一微生物群體中的不同細胞用接種環在平板培養基表面通過分區劃線稀釋而得到較多獨立分布的單個細胞,經培養後生長繁殖...
原理 步驟 特點 示例平板劃線分離法是指把混雜在一起的微生物或同一微生物群體中的不同細胞用接種環在平板培養基表面通過分區劃線稀釋而得到較多獨立分布的單個細胞,經培養後生長繁殖...
方式 目的 步驟1.通過平板劃線而獲得微生物純培養物的方法,又稱平板劃線法。是指把混雜在一起的微生物或同一微生物群體中的不同細胞,用接種環在平板表面上作多次由點到線的劃...
簡介 方式 注意點平板培養,是指將瓊脂或明膠等凝膠狀固體培養基製成平面狀,然後在此平面上接種微生物或多細胞生物的細胞、組織或器官,並進行培養的方式稱為平板培養。平板培養一...
分離培養是對微生物進行研究的一種方法,目的在於從自然物上混雜的微生物群體中獲得所需要的純種微生物。分離培養常在固體平板培養基上用劃線分離法或液體稀釋法或...
真菌分離培養是將臨床檢驗標本劃線分離接種或插種於真菌培養基內,並置於合適的生長環境進行孵育獲得真菌純種的過程。真菌繁殖既可以是有性繁殖也可以是無性孢子繁...
培養方法 臨床意義抑菌圈法又叫擴散法,是利用待測藥物在瓊脂平板中擴散使其周圍的細菌生長受到抑制而形成透明圈,即抑菌圈,根據抑菌圈大小判定待測藥物抑菌效價的一種方法。抑菌圈...
微生物學實驗中的一種操作方法。由於將含菌材料現加到還較燙的培養基中再倒平板易造成某些熱敏感菌的死亡,而且採用稀釋倒平台法也會使一些嚴格好氧菌因被固定在瓊...
特徵 實驗器材 實驗方法